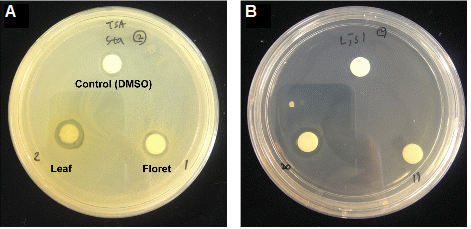
http://static.apub.kr/journalsite/sites/kshs/2014-032-03/N0130320317/images/PICC1E7.gif
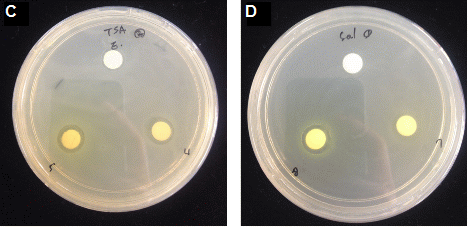
http://static.apub.kr/journalsite/sites/kshs/2014-032-03/N0130320317/images/PICC2F2.gif

서 언
최근 인간수명의 연장으로 식품의 섭취가 단지 영양원으로 신체유지라는 제한된 역할에서 벗어나 건강한 삶을 오래 유지하기 위한 보건 기능성식품의 역할로 주목 받고 있으며, 이에 노화억제와 건강유지를 위한 연구가 광범위하게 이루어지고 있다(Granato et al., 2010). 그 중 채소와 과일의 섭취는 항암, 항노화, 항당뇨, 항세균력을 증진시키는 역할을 하고 있으며(Khaw et al., 2001), 이러한 작용을 하는 생리활성 물질에 관한 연구가 미생물과 식물분야에서 활발히 진행되고 있다(Fyhrquist et al., 2002; Rauha et al., 2000; Stangeland et al., 2009).
노화와 질병은 인체 내의 활성산소에 의해 생체 내에서 단백질의 불활성화, 세포막 분해, 세포구조 손상, DNA 합성억제, 지방 산화 등 생리적인 장애에 의해 유발된다(Gardner and Fridovich, 1991; Imlay and Linn, 1988). 인체 내에서는 SOD(superoxide dismutase), catalase, glutathione reductase 등의 항산화 효소와 천연 항산화제 등이 존재하여 활성산소를 제거해 생체를 보호하는 방어시스템을 가지고 있지만, 여러 요인들에 의해 항산화 방어시스템의 균형이 깨져 노화와 각종 질병을 일으키게 된다(Yildirim et al., 2001). 따라서 항노화와 질병의 예방을 위해 효과적인 항산화제의 섭취가 필요한 것이다. 이에 tocopherols, vitamin C, carotenoids, catechins 등과 같은 천연 항산화제와 BHT(butylated hydroxytoluene), BHA(butylated hydroxyanisole), PG(propyl gallate), TBHQ (tert-butylhydroquinone)등의 합성 항산화제가 이용되고 있지만, tocopherols의 높은 가격과 BHT, BHA의 독성에 대한 안전성 문제로 인해 천연물로부터 안전성과 항산화력이 높은 물질을 이용하려는 연구가 이루어 지고 있다(Cha et al., 2000; Hatano, 1995; Masaki et al., 1995).
주요 식중독 원인균으로 황색포도상구균(Staphylococcus aureus), 살모넬라균(Salmonella enteritidis), 리스테리아균(Listeria monocytogenes), 병원성 대장균(Escherichia coli O157:H7) 등이 있는데, 이들을 억제하기 위해 사용되어지는 화학 합성 보존제의 사용에 대한 기피현상 또한 나타나고 있어, 이 균들에 대한 항균 물질을 식물로부터 찾기 위한 연구도 진행되고 있다(Jayaprakasha et al., 2003; Kim et al., 2011; Lee and Shin, 1991). 배추과 작물 또한 식물성 이차 대사물질인 glucosinolates, flavonoids, polyphenols 등의 물질이 풍부하게 존재함이 밝혀져(Fenwick and Heaney, 1983), 항산화, 항균 활성에 관한 연구가 활발하게 진행되어 왔다(Andarwulan et al., 2010; Ayaz et al., 2008; Dasgupta and Bratati, 2007; Kyung and Fleming, 1994). 배추과 작물 중 브로콜리(Brassica oleracea var. italica)에는 항산화 활성을 가진 ß-carotene, ascorbic acid, rutin, glutathione, quercetin, selenium 등이 다량 함유되어 있으며(Sok et al., 2003), glu-cosinolates의 효소적 가수분해 산물 중의 하나로서 고혈압예방, 심혈관 질환예방, 암세포의 증식을 억제하는 등의 역할을 하는 sulforaphane이 많이 함유되어 있는데(Zhang et al., 1992), 그 함량이 브로콜리, 순무, 무, 무잎, 흰색 양배추, 자색 양배추, 케일, 콜리플라워, 배추, 청경채, 갓, 돌산갓, 무순, 배추뿌리 등의 배추과 채소들 중에서 가장 높았다는 보고가 있다(Kim et al., 1997).
이러한 기능성 채소로서의 특성들로 인하여 브로콜리는 세계적으로 큰 시장을 형성하고 있으며, 2000년대 이후 국내에서도 소비가 급증하고 있으나 작은 꽃봉오리가 다발로 이루어진 화뢰(floret) 부위만을 식용하기 때문에 잎 부위는 모두 버려지고 있다. 따라서 본 연구에서는 브로콜리의 품종 및 화뢰와 잎 부위로 나누어 주요 식중독균에 대한 항균효과와 항산화 활성을 비교 분석함으로써 추후 고기능성 품종의 육성과 폐기되는 잎 부위를 활용하기 위한 기초자료를 얻고자 수행되었다.
재료 및 방법
실험 재료
본 실험에 사용된 시료는 경기도 수원시 국립원예특작과학원 재배포장에서 재배한 브로콜리 11개 품종을 화뢰, 잎 부분으로 나누어 동결 건조한 후 분쇄하여 분말을 사용하였다.
추출물 제조
동결건조한 브로콜리 분말시료에 10배의 70% 메탄올을 첨가한 후, 상온에서 24시간 교반 추출한 추출액은 여과지(Whatman No. 6)로 여과한 다음 회전감압농축기(N-1NW, EYELA, Japan)로 감압농축 후 동결 건조하여 -20°C에서 냉동보관하면서 본 실험의 시료로 사용하였다.
사용균주 및 배양조건
실험에 사용한 균주는 식중독을 유발하는 대표적인 균주로 그람 양성균 Staphylococcus aureus subsp. aureus KCCM 11335, Listeria monocytogenes KCCM 40307 2종과 그람 음성균 Escherichia coli O157:H7 KCCM 40406, Salmonella enteritidis KCCM 12021 2종을 한국미생물보존센터(KCCM, Seoul, Korea)에서 분양 받아 사용하였으며 사용된 배지의 조건은 Table 1과 같다. 각 배지는 121°C에서 20분간 멸균하였으며 멸균된 petri dish에 약 20mL씩 분주하여 사용하였다.
항균활성 측정
브로콜리 품종 및 부위별 추출물의 항균활성은 paper disc 확산법으로 측정하였다(Bauer et al., 1966). 해당 평판배지에 균주를 streaking하여 배양된 균주 1 백금이를 취해 10mL의 균 생육배지에 접종하고 37°C에서 24시간 배양하여 활성화시킨 후 3일간 배양 후 spectrophotometer(ND-1000, Nano Drop Technologies, Inc., USA)를 이용하여 600nm에서 균 현탁액의 흡광도가 0.3이 되게 하였다. 각 균주 배양액을 평판배지에 200µL씩 고르게 도말한 후 배지의 표면 위에 멸균된 paper disc(8mm, Toyo Roshi Kaisha, Ltd., Japan)를 올려놓고 추출물을 disc에 50µL씩 주입하여 완전히 흡수시킨 후 37°C incubator에서 24시간 배양시켜 paper disc 직경을 포함한 주위의 저해환(inhibition zone, mm)의 직경을 측정하였다.
항산화효과 측정
브로콜리 부위별 항산화 효과의 측정은 DPPH(2,2-Diphenyl- 1-pikryl-hydrazyl) 라디칼 소거 방법을 사용하였다. 80% 메탄올을 이용하여 400µM의 DPPH 용액을 제조 후, 96 well plate를 사용하여 80% 메탄올에 1mg・mL-1 농도로 녹인 100µL의 시료와 100µL의 DPPH 용액을 첨가하였다. 30분 후, micro plate reader(EON-C, BioTek Instruments., USA)를 이용하여 517nm에서 흡광도를 측정하였다. 대조구의 흡광도도 같은 조건에서 3회 반복측정하였으며, 이들 측정값을 다음의 electron donating ability(EDA%) 식에 대입하여 DPPH 라디칼 소거활성을 계산하였다.
EDA(%) = (BCONTROL-ASAMPLE)/BCONTROL × 100
ASAMPLE: 실험구(분획 첨가)의 흡광도
BCONTROL: 음성대조구(분획 미첨가)의 흡광도
통계처리
실험결과는 3회 반복 측정 후 SAS 통계패키지(ver. 9.2, Cory, NC, USA)를 이용하여 평균 ± 표준편차로 나타내었으며, 통계적 유의성은 Duncan’s multiple test로 검정하였다.
결과 및 고찰
추출수율
동결건조한 브로콜리 분말로부터 70% 메탄올 추출물의 추출 수율은 Table 2와 같다. JN 품종의 추출수율이 화뢰와 잎 부위 모두 17.8%, 26.0%로 가장 높게 나타났으며, 품종마다 추출수율의 차이를 보였는데 이는 각 품종마다 가지고 있는 수분의 함량, 조직 치밀도, 물질 성분 등의 차이에 따른 것으로 사료된다. 부위별 평균값은 화뢰는 14.1%, 잎은 18.7%의 추출수율을 나타내었다.
항균활성
브로콜리 메탄올 추출물의 항균활성을 국내 주요 식중독 원인균 4종에 대해 비교하였다(Table 3 and Fig. 1). 그람 양성균인 S. aureus는 황색 색소를 생성하여 황색포도상구균으로 불리며 식중독 뿐만 아니라 화농성 감염증, 폐렴, 골관절염 등을 유발하는 유해 세균이다(Kim et al., 2010). S. aureus에 대한 항균력을 살펴보면, AMG 품종에서 화뢰 추출물 12.83mm, 잎 추출물 13.00mm의 가장 높은 항균활성을 보였으나, 부위별로는 큰 차이를 보이지 않았으며, 대조군으로 사용한 DMSO도 저해환을 나타냄으로서 DMSO가 S. aureus에 대해 생물학적 독성이 있는 것으로 판단되었다. L. monocytogenes는 리스테리아증(listeriosis)을 일으켜 면역이 낮은 환자, 유아, 임산부 등에 패혈증, 뇌수막염, 유산 등을 일으키며, 사망에까지 이를 수 있는 식중독균으로 낮은 온도에서도 생육이 가능하여 냉장식품에 문제가 되고 있는 균이다(Farber and Peterkin, 1991). L. monocytogenes의 경우, 화뢰 추출물은 NJ 품종이 13.58mm, 잎 추출물은 YDR 품종이 13.92mm의 항균활성을 보임으로서 가장 항균력이 뛰어났다. 부위별로는 각 품종마다 항균활성의 차이는 보였으나, 저해환의 평균 값이 화뢰 추출물 12.85mm, 잎 추출물 13.17mm로 다른 4종의 균 중에서 가장 높은 값을 보였다.
Jaiswal et al.(2012)은 브로콜리, brussel sprouts, 백색 양배추에 대하여 L. monocytogenes, Pseudomonas aeruginosa, Salmonella abony, Enterococcus faecalis에 대한 항균활성을 살펴본 결과, 브로콜리 추출물이 4종의 균에 대해 항균력이 가장 높았음을 보고하였다.
그람 음성균인 E. coli O157:H7은 다양한 식품과 물을 통해 사람에게 감염되며 사람간 전이가 가능한 것으로 보고되어 있으며, 일본에서 1996년 1만명 이상의 환자가 발생한 대표적인 식중독 균으로 국내에서도 지속적으로 발병 사례가 일어나고 있는 추세로서(Lim et al., 2008), 브로콜리 추출물의 항균활성을 살펴보면 Grd 품종이 화뢰와 잎 부위 모두 가장 높은 항균활성을 보였으나 부위별로는 차이가 나타나지 않았다. S. enteritidis는 장내세균과에 속하는 그람 음성균으로 가금류와 돼지에 널리 분포하며, 사람을 포함한 모든 동물에 감염하여 장염과 패혈증을 일으킬 수 있는데, 미국, 캐나다, 유럽 등의 국가에서 S. enteritidis가 사람에 감염된 경우가 급격히 증가해 왔으며, 국내에서도 Salmonella속 균 가운데 S. enteritidis에 의한 감염증이 현저히 증가하고 있다(Kang, 2012). S. enteritidis에 대한 항균활성을 살펴보면, 화뢰 추출물은 NJ 품종이 12.67mm, 잎 추출물은 NY, 0c 품종이 12.75mm의 저해환을 보였으며, 부위별로는 잎 추출물이 12.36mm로 화뢰 추출물 11.89mm 비해 높은 항균활성을 보여주었다.
Lee and Park(2005)은 브로콜리 부위별 추출물을 10% 농도로 제조하여 121°C에서 15분간 고온・고압처리한 후 항균성 검정을 한 결과, E. coli와 Salmonella typhimurium에서는 전혀 항균성을 보이지 않았고, 그람 양성균 중 Bacillus amyloliquefaciens에서 꽃과 꽃-줄기 추출물이 가장 두드러진 항균성을 보였고 잎 추출물에서도 항균성이 크지는 않지만 항균활성을 관찰할 수 있다고 하였는데 이는 가열에 의해 그 활성이 감소한 것으로 판단된다.
항산화 효과
전자공여능(EDA, %) 측정에 사용된 DPPH는 비교적 안정한 free radical로서 아스코르빈산, 토코페롤, 방향족 아민류 등에 의해 환원되어 짙은 자색이 탈색됨으로써 전자공여능의 차이 측정이 가능하여 항산화 효과를 평가하는데 많이 이용되고 있다(Shin et al., 2008). 브로콜리 품종 및 부위별 DPPH 라디칼 소거활성을 측정한 결과는 Fig. 2와 같다. 품종별로 살펴보면 화뢰 추출물은 NJ 품종이 39.90%, 잎 추출물은 0c 품종이 43.64%로 가장 높은 항산화 활성을 보였으며, 부위별 평균값은 화뢰 추출물 23.53%, 잎 추출물 35.91%를 나타내어 잎 추출물의 항산화 효과가 약 1.5배 높음을 볼 수 있었다. NJ 품종을 제외하고 모든 품종에서 잎 추출물의 전자공여능이 화뢰 추출물보다 높은 값을 나타내었다.
Jaiswal et al.(2011)은 브로콜리와 york cabbage, 백색 양배추, brussel sprouts의 배추과 작물과의 항산화 효과를 비교한 결과, 브로콜리 추출물이 가장 높은 항산화 효과가 있음을 보고하였고, Kim et al.(1999)의 연구에서 케일 및 브로콜리 잎즙의 Vitamin C 함량을 비교한 결과, 케일에는 101 mg%이었는데, 브로콜리 잎 8품종 모두 125-179mg%로 케일보다 많았다는 연구 결과가 있다.
이상의 결과를 종합해 볼 때, NJ 품종의 화뢰 추출물이 L. monocytogenes, S. enteritidis에 대해 가장 높은 항균활성을 나타내었으며, 항산화 활성도 가장 뛰어남으로 항균, 항산화 효과를 가진 기능성 품종으로 판매 가능할 것으로 여겨졌다. 부위별 차이를 살펴보면, 품종마다 차이를 보이지만 잎 추출물이 화뢰 추출물보다 L. monocytogenes, S. enteritidis에 대해 높은 항균활성을 보였다. 항산화 효과 역시 잎 추출물의 전자공여능이 화뢰 추출물보다 약 1.5배 높음을 알 수 있었다. 이를 통해 브로콜리의 화뢰뿐만 아니라 잎의 항균력, 항산화 효과 또한 뛰어남을 알 수 있었고, 이는 현재 버려지고 있는 브로콜리 잎을 쌈채 혹은 녹즙으로 식용함으로써 국민의 보건 향상은 물론, 농가의 새로운 부수입원으로서 소득 증대에 기여 가능 할 것으로 기대된다. 더불어 이러한 신속, 간편 항균력 측정법과 항산화능 측정법은 기능성 브로콜리 품종 육성에 있어 대량의 후보 계통 중, 유망 계통만의 신속 선발에도 큰 도움이 될 것으로 판단된다.